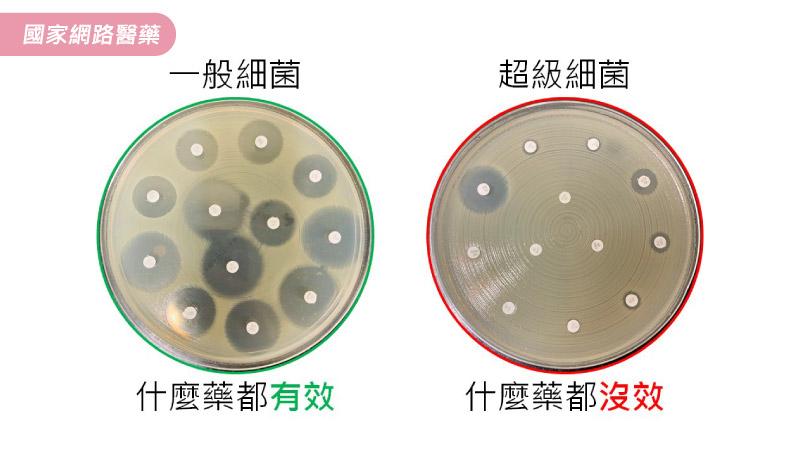

報導/黃慧玫 圖片設計/Anita 諮詢專家&圖片提供/林口長庚紀念醫院檢驗醫學部主治醫師 王信堯、林口長庚紀念醫院檢驗醫學部主任 盧章智 圖片來源/ Freepik
全球正面臨超級細菌擴散、抗藥性日益嚴重等問題!你知道嗎,全球每年有70萬人死於抗藥性;到了2050年,每3秒就可能有1人死於抗藥性。這是因為抗生素濫用,導致具抗藥性的「超級細菌」產生,使患者面臨無藥可用窘境。
能抵抗3種以上抗生素的細菌,就稱為「超級細菌」。抗藥性極強� �「超級細菌」,未來除可能面臨無藥可醫狀況外,另外更須面對的是,由於無法使用臨床的檢驗方法檢驗而出,不但加重治療困難度,錯誤用藥更增強其抗藥能力。
為突破「超級細菌」檢驗困境,林口長庚醫院與長庚大學、中央大學跨領域合作,運用AI人工智慧開發出「超級細菌預測模型」,可更快速、正確地進行微生物特性鑑定,幾秒鐘內即可完成預測,並達到80%的用藥準確性,成為對抗微生物感染的一大利器。
林口長庚紀念醫院檢驗醫學部主治醫師王信堯表示,微生物學家已經發現不少超級細菌,例如金黃色葡萄球菌、腸球菌、鮑曼不動桿菌等。其中,金黃色葡萄球菌最廣為人知,但盤尼西尼(青黴菌)的發現,使人類不再因小傷口就感染死亡。
而在抗生素濫用狀況下,卻使得金黃色葡萄球菌抗藥力不斷增強,治療愈來愈不容� �。王信堯說明,通常萬古黴素已是治療抗藥性金黃色葡萄球菌MRSA的最後藥物,但,目前已出現可對抗萬古黴素的金黃色葡萄球菌Hvisa的究極細菌。
林口長庚紀念醫院檢驗醫學部主任盧章智表示,超級細菌對健康照護所帶來的挑戰日益嚴峻!已有本土及國際的研究指出,超級細菌的盛行率高達7.5%;世界衛生組織甚至預測,到2050年,將無合適的抗生素可治療感染症。
在這個越來越多「超級細菌」異軍突起的年代,除了關注是否有突破性的新藥可對抗外,還須檢視超級細菌是否能在第一時間被檢驗單位檢測出來!王信堯解釋,抗藥性超級細菌有時可被檢測出來,但大多數卻常躲藏在無抗藥力的菌群中,其比例甚至低到10~100萬隻細菌中才有一隻存在,使得臨床檢測出現完全無法檢測到的難關。
導致感染症病患到院後,由於無法即時偵測� ��體內的超級細菌,往往必須歷經多種藥物嘗試、治療失敗、嚴重併發症等過程後,才有辦法證實超級細菌的存在與種類,並對症下藥。王信堯提到,不但加重治療困難度,反覆錯誤用藥更增強其抗藥能力。
因此,林口長庚醫院於多年前就高度重視微生物檢驗的重要性,引進並臨床使用質譜儀(MALDI-TOF),廣泛用於微生物菌種的鑑定。研究團隊利用其所產生的數據,進一步使用人工智慧分析技術,成功從大數據中解讀出超級細菌可能的抗藥機制,就能成功預測超級細菌。
王信堯說,利用「超級細菌預測模型」進行微生物特性鑑定,只需要使用質譜儀資料即可,不須額外的檢驗操作,幾秒鐘即可完成預測;經過反覆驗證後,其正確率可達80%,具高精準度和高時效性;且每次操作都能產出相同結果,不會因操作人員不同而有結果差異,減少許� ��額外的檢驗操作及人為判讀。
目前,「超級細菌預測模型」技術已可運用於臨床微生物之檢驗,並應用在臨床實務,可以快速的檢測到臨床方法無法偵測得的超級細菌,幫助醫師提早數天得知病患是否為超級細菌感染,以進一步更準確的施用正確抗生素,治療不再多走冤枉路,更能有效降低感染惡化成敗血症,甚至死亡的憾事發生。
盧章智進一步說明,「超級細菌預測模型」的臨床使用成效顯著,除已申請專利,這項研究成果更榮獲2017年台北國際發明展金獎,並刊登於2018年10月國際微生物研究學界著名期刊「微生物研究先驅(Frontiers in Microbiology)」。
目前,研發團隊也將此人工智慧發明方法廣泛運用於其他超級細菌,逐步進行各超級細菌抗藥性預測研究,希望可將此技術推廣應用至更多重要的超級細菌,以期建置一超級細菌預測� ��台,造福更多病患。
本文轉載自 KingNet國家網路醫藥
沒有留言:
張貼留言